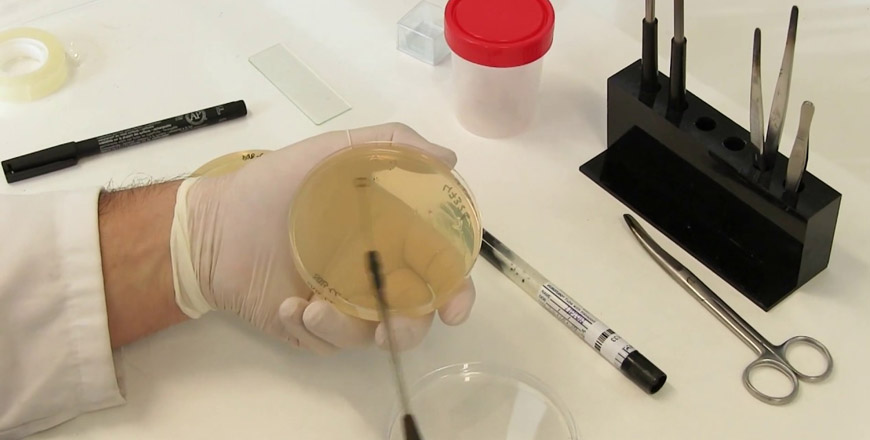

Área Micología
Exámenes Parasitológicos:
- Cultivo De Hongos (25 Días)
- Examen Directo Al Fresco.
PREGUNTAS FRECUENTES
¿Qué es el examen de micología y para qué sirve?
Es una prueba que detecta la presencia de hongos en el cuerpo. Sirve para diagnosticar infecciones fúngicas en la piel, uñas, cabello o en órganos internos, especialmente en personas con sistemas inmunológicos comprometidos.
¿Qué tipos de infecciones fúngicas se pueden detectar con este examen?
Puede identificar infecciones como candidiasis, dermatofitosis (tiña), aspergilosis y criptococosis. También detecta infecciones más raras pero graves causadas por hongos invasivos.
¿Qué muestras se utilizan para los exámenes de micología?
Dependiendo de la sospecha clínica, se pueden analizar muestras de piel, uñas, cabello, sangre, orina, secreciones respiratorias o tejidos infectados.
¿Cómo debo prepararme para un examen de micología?
La preparación depende del tipo de muestra. Por ejemplo, si es una muestra de uñas o piel, evita aplicar cremas o medicamentos tópicos antes del examen. Si es una muestra respiratoria, sigue las instrucciones del laboratorio para obtener la muestra adecuada.
¿Cuánto tiempo tardan los resultados del examen de micología?
Los resultados básicos pueden estar disponibles en 1 o 2 días. Sin embargo, cultivos fúngicos para identificar el tipo de hongo pueden tardar hasta varias semanas debido al lento crecimiento de algunos hongos.
¿Qué sucede si el resultado del examen muestra una infección fúngica?
El médico interpretará los resultados y recetará un tratamiento antifúngico específico según el tipo de hongo y la gravedad de la infección. En infecciones severas, puede ser necesario realizar más pruebas para evaluar la extensión de la infección.

55 2 686244